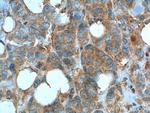
MCT1 Antibody in Immunohistochemistry (Paraffin) (IHC (P))

Search
Proteintech
MCT1 Polyclonal Antibody
{{$productOrderCtrl.translations['antibody.pdp.commerceCard.promotion.promotions']}}
{{$productOrderCtrl.translations['antibody.pdp.commerceCard.promotion.viewpromo']}}
{{$productOrderCtrl.translations['antibody.pdp.commerceCard.promotion.promocode']}}: {{promo.promoCode}} {{promo.promoTitle}} {{promo.promoDescription}}. {{$productOrderCtrl.translations['antibody.pdp.commerceCard.promotion.learnmore']}}
产品信息
20139-1-AP
种属反应
已发表种属
宿主/亚型
分类
类型
抗原
偶联物
形式
浓度
规格
纯化类型
保存液
内含物
保存条件
运输条件
产品详细信息
Immunogen sequence: EQKANEQKK ESKEEETSID VAGKPNEVTK AAESPDQKDT DGGPKEEESP V (451-500 aa encoded by BC026317)
靶标信息
SLC16A1 is a monocarboxylate transporter (MCT1) that mediates the movement of lactate and pyruvate across cell membranes. Import and export of these substrates by tissues such as erythrocytes, muscle, intestine, and kidney are ascribed largely to the action of a proton-coupled MCT.
仅用于科研。不用于诊断过程。未经明确授权不得转售。
生物信息学
蛋白别名: FLJ36745; MCT 1; MGC44475; monocarboxylate transporter; Monocarboxylate transporter 1; SLC16A1 protein; solute carrier family 16 (monocarboxylate transporter), member 1; solute carrier family 16 (monocarboxylic acid transporters), member 1; Solute carrier family 16 member 1; solute carrier family 16, member 1 (monocarboxylic acid transporter 1); unnamed protein product
基因别名: AL022710; HHF7; MCT; MCT1; MCT1D; SLC16A1
UniProt ID: (Human) P53985, (Mouse) P53986
Entrez Gene ID: (Human) 6566, (Mouse) 20501